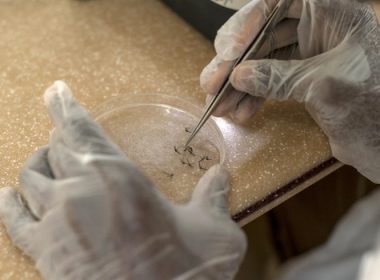
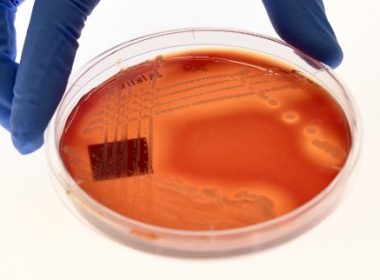

LONDON, United Kingdom (AFP) — Pharmaceutical giants GlaxoSmithKline and Pfizer on Wednesday announced a merger of their consumer healthcare units that produce over-the-counter medicines. GSK said it would have a 68-percent controlling equity interest in the joint venture that will have combined sales of about £9.8 billion ($12.7 billion, 10.9 billion euros). The deal paves the way for British group GSK to have two UK-listed companies, one specialised in the development of drugs and the […]
Health
Scientists create bee vaccine to fight off ‘insect apocalypse’
HELSINKI, Finland (AFP)- Scientists in Finland have developed what they believe is the world’s first vaccine to protect bees against disease, raising hopes for tackling the drastic decline in insect numbers which could cause a global food crisis. Bees are vital for growing the world’s food as they help fertilize three out of four crops around the globe, by transferring pollen from male to female flowers. But in recent years bee populations around the world have been […]
Researchers explore new way of killing malaria in the liver
by Ivan COURONNE with Nathalie OLOF-ORS in Basel Agence France-Presse WASHINGTON, United States (AFP) — In the ongoing hunt for more effective weapons against malaria, international researchers said Thursday they are exploring a pathway that has until now been little studied — killing parasites in the liver, before the illness emerges. “It’s very difficult to work on the liver stage,” said Elizabeth Winzeler, professor of pharmacology and drug discovery at University of California San Diego […]
Heavy screen time appears to impact childrens’ brains: study
WASHINGTON, United States (AFP) — Researchers have found “different patterns” in brain scans among children who record heavy smart device and video game use, according to initial data from a major ongoing US study. The first wave of information from the $300 million National Institute of Health (NIH) study is showing that those nine and 10-year-old kids spending more than seven hours a day using such devices show signs of premature thinning of the cortex, […]
E. coli lettuce outbreak traced to California
NEW YORK, United States (AFP) — An outbreak of E. coli linked to romaine lettuce appears to have been traced to crops in California, the US food authority said Monday. American consumers were warned against eating the leafy salad by health officials last week. The outbreak has caused 43 people to become sick in the US and another 22 in Canada, according to the Food and Drug Administration (FDA). “Our investigation at this point suggests […]
Germany’s ‘killer nurse’ tells families of over 100 victims ‘sorry’
BERLIN, Germany (AFP) — A German former hospital nurse who has admitted to killing more than 100 patients in his care apologized Thursday to victims’ grieving relatives. “If I knew a way that would help you, then I would take it, believe me,” Niels Hoegel, 41, said at his trial, according to national news agency DPA. “I am fully convinced now that I owe every relative an explanation,” said the bearded, heavyset defendant “I am […]
Probiotics no help to kids with stomach flu: studies
by Kerry SHERIDAN Agence France Presse TAMPA, United States (AFP) — Probiotics are a multibillion dollar international industry, but new research Wednesday showed they don’t help children recover from stomach flu any better than a placebo. The results of two randomized clinical trials — which came to the same conclusions — were published in the New England Journal of Medicine. “Probiotics had no effect on the children,” said co-author Phillip Tarr, a professor of pediatrics […]
US issues health alert on romaine lettuce
WASHINGTON, United States (AFP) — US health officials warned consumers Tuesday not to eat any romaine lettuce and to throw away any they might have in their homes, citing an outbreak of E. coli poisoning. The Centers for Disease Control and Prevention (CDC) issued the warning against all Romaine lettuce just two days before the Thanksgiving holiday, when American families gather and feast together. “Consumers who have any type of romaine lettuce in their home […]
WHO maps dangerous misuse of antibiotics
GENEVA, Switzerland (AFP) — The World Health Organization warned Monday that antibiotics consumption is dangerously high in some countries while a shortage in others is spurring risky misuse, driving the emergence of deadly superbug infections. In a first, the United Nations health agency said it had collated data on antibiotic use across large parts of the world and had found huge differences in consumption. The report, based on 2015 data from 65 countries and regions, […]
Pneumonia to kill nearly 11 mn children by 2030, study warns
PARIS, France (AFP) — Pneumonia will kill nearly 11 million children under five by 2030, experts warned Monday on a global day aimed at raising awareness of the biggest infectious killer of infants worldwide. While in the developed world the severe lung infection mainly affects the elderly, in developing nations it is children who bear the brunt, with hundreds of thousands dying each year from the easily preventable disease. More than 880,000 children — mainly […]
Superbugs to ‘kill millions’ by 2050 unless countries act
by Patrick Galey Agence France Presse PARIS, France (AFP) — Millions of people in Europe, North America and Australia will die from superbug infections unless countries prioritize fighting the growing threat posed by bacteria immune to most known drugs, experts predicted Wednesday. The Organisation for Economic Co-operation and Development (OECD) warned of “disastrous consequences” for public healthcare and spending unless basic hospital hygiene is boosted and unnecessary antibiotic use slashed. Drug-resistant bacteria killed more […]
Publiko, pinag-iingat ng DOH sa pagbili ng battery operated devices
Ni Belle Surara Eagle News Reporter (Eagle News) – Muling pinayuhan ng Department of Health (DOH) ang publiko na maging maingat sa pagbili ng mga produkto online lalo na ang mga battery operated devices. Ayon kay Health Secretary Francisco Duque III, ang mga naturang devices ay hindi laruan. Ito aniya ay nagtataglay din ng tinatawag na “concomitant health at safety hazards”. Magugunita na isang binatilyo ang nasabugan ng vape sa bibig matapos umanong makipag-swap ng […]